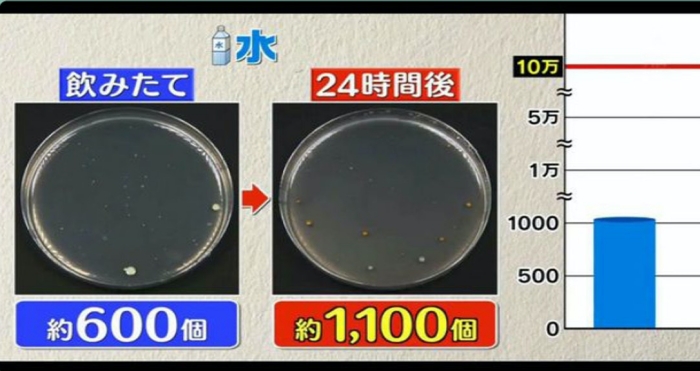
health-sep30-water.jpg health-sep30-water.jpg
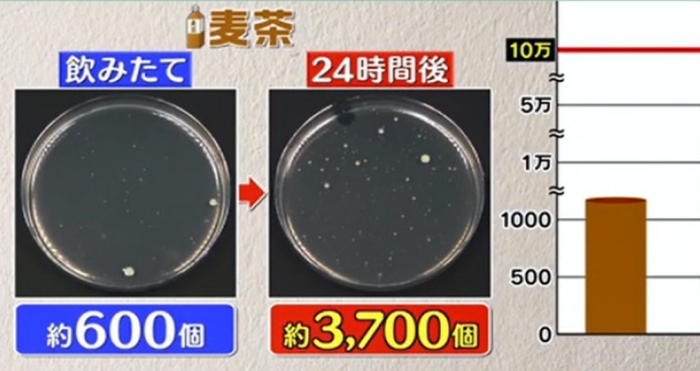
health-sep30-maicha.jpg health-sep30-maicha.jpg
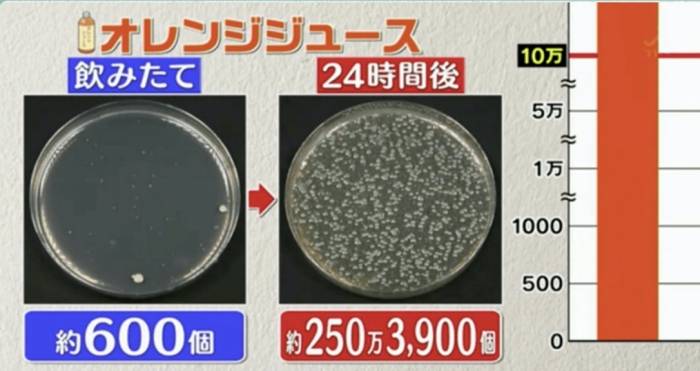
health-sep30-orange-juice.jpg health-sep30-orange-juice.jpg
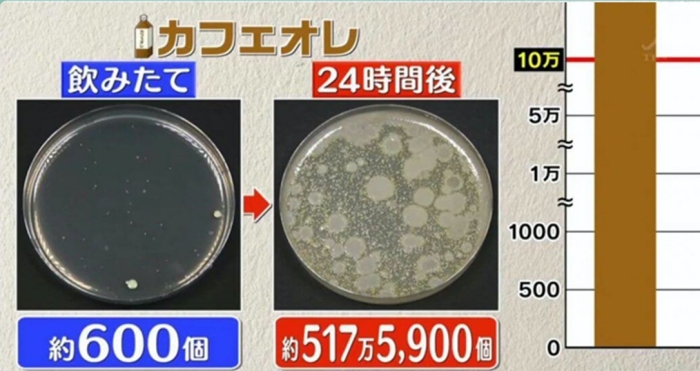
health-sep30-milk-coffee.jpg health-sep30-milk-coffee.jpg

文+整理:阿宝 / 图:互联网
日本节目《月曜から夜ふか》日前为 5 款常见饮品进行实测,将饮品开封饮用后,放在温室 24 小时,发现饮品含菌量暴增!
节目中还邀请来了,东京大学农业生命科学研究科教授为大家解答疑惑,首先教授为 5 种饮品进行金葡萄球菌检测,结果发现有 5 款饮品的金葡萄球菌的数量在隔夜受大幅增加!
NO 5 水
喝饮料的时候我们的唾液碰到瓶口,细菌就会开始增长!而水的含菌量从 600 个,增加至1100个!
NO 4 大麦茶
大麦茶含有糖分和蛋白质,是细菌滋生的必要养分!而大麦茶的含菌量从 600 个,增加至 3700 个!
NO 3 可乐
可乐属于高糖饮品,而高糖环境非常适合金葡萄球菌滋生,可乐的含菌量从 600 个,增加至 249 万 3800 个!

NO 2 鲜橙汁
鲜橙汁本身含有果糖,加剧了细菌滋生!鲜橙汁的含菌量从 600 个,增加至 250 万 3900 个!
NO 1 咖啡牛奶
咖啡牛奶的含菌量从 600 个,增加至 517 万 5900 个!而台湾医院外科医生曾表示,这类隔夜饮品的细菌量,甚至比马桶还要脏 40 倍!
什么是金葡萄球菌?
根据卫生防护中心和食物安全中心的资料显示,金葡萄球菌通常存在人类的鼻孔、咽喉、头发甚至肌肤,但一般都不会引起任何的不适。但如果食物收到了金葡萄球菌污染,并且在温室存放过久,就会容易让金葡萄球菌迅速繁殖,并产生耐热肠毒素,会引发食物中毒等症状。

如何避免细菌滋生?
将已经开封饮用的饮品放在室温摄氏 28 度的环境,是有利于细菌滋生的!所以建议大家将开封后的饮品放入冰箱保存,这样可以有效抑制细菌增长!
+++++++++++++++++++++++++++++++++++
【吃货必看!】Bangsar素食餐厅推荐!让你从此爱上素食~